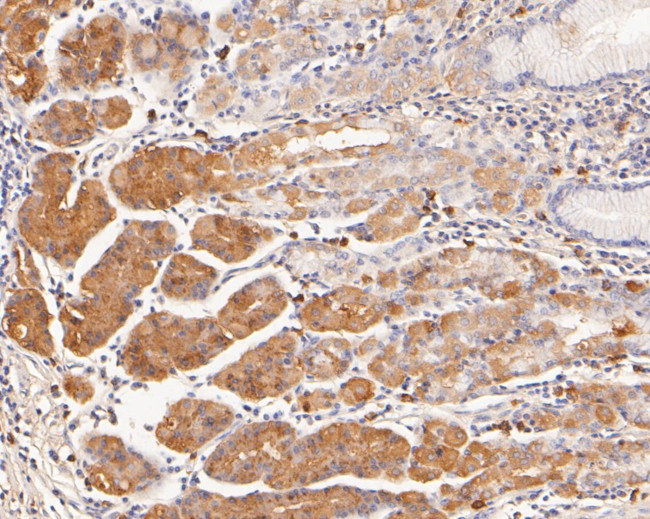
Histamine H2 receptor Antibody in Immunohistochemistry (Paraffin) (IHC (P))

Search
Huabio
Histamine H2 receptor Polyclonal Antibody
{{$productOrderCtrl.translations['antibody.pdp.commerceCard.promotion.promotions']}}
{{$productOrderCtrl.translations['antibody.pdp.commerceCard.promotion.viewpromo']}}
{{$productOrderCtrl.translations['antibody.pdp.commerceCard.promotion.promocode']}}: {{promo.promoCode}} {{promo.promoTitle}} {{promo.promoDescription}}. {{$productOrderCtrl.translations['antibody.pdp.commerceCard.promotion.learnmore']}}
图: 1 / 2
Histamine H2 receptor Antibody (HA500154) in IHC (P)


产品信息
HA500154
种属反应
宿主/亚型
分类
类型
抗原
偶联物
形式
浓度
规格
纯化类型
保存液
内含物
保存条件
运输条件
靶标信息
H2 Histamine Receptor stimulates adenylate cyclase activity and leads to the release of acids in the stomach. It is also involved in GI motility and intestinal secretion. Treatments for acid-peptic disorders are based on the inhibition of histamine H2 receptor activity. The 3-untranslated region may be involved in differential expression. Histamine H2 receptor has been reported to be expressed in bone marrow, brain, heart, lymph node, nose, placenta, spinal cord, and stomach. An EST has been isolated from a kidney library.
仅用于科研。不用于诊断过程。未经明确授权不得转售。
篇参考文献 (0)
生物信息学
蛋白别名: gastric receptor 1; Gastric receptor I; H2R; Histamine H2 receptor; histamine receptor
基因别名: H2R; HH2R; HRH2
UniProt ID: (Human) P25021
Entrez Gene ID: (Human) 3274